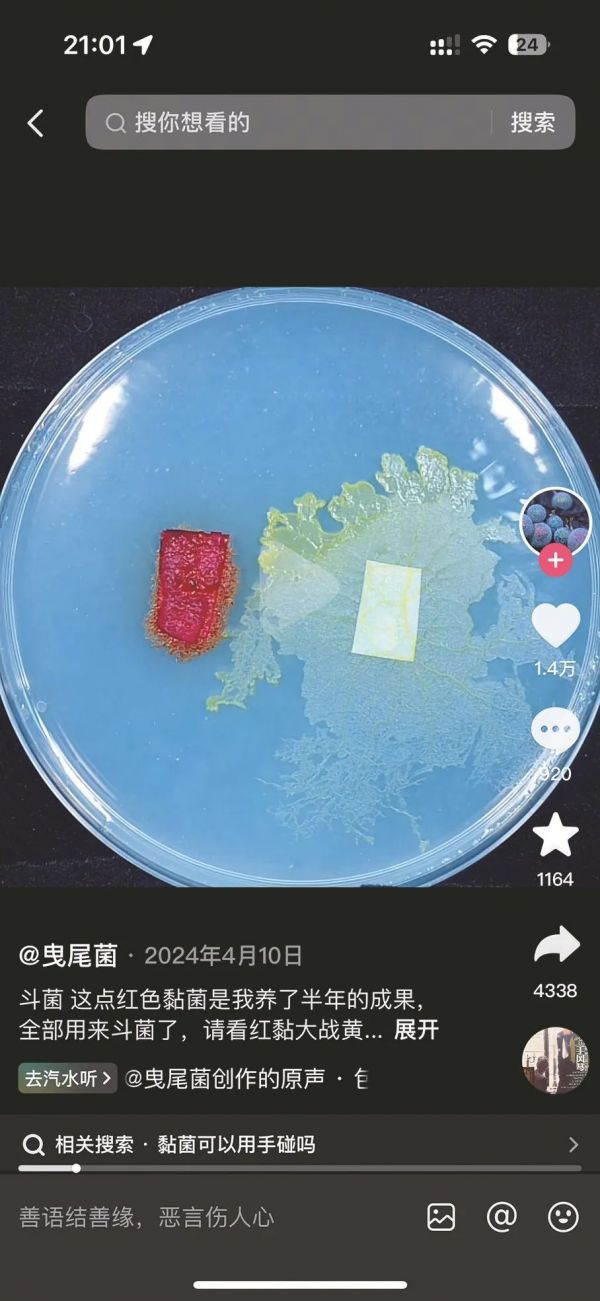

近年来,宠物定义的边界不断拓宽。继养石头、纸盒、“芒狗”(芒果核)、黏菌等静态异宠后,一阵更具科幻色彩的“面蛊”风潮正席卷社交网络。这种通过混合面粉、水和酵母发酵形成的“生物艺术品”迅速在网络上引发热议,成为年轻人追求新奇体验、寻找心灵慰藉的新选择。
“面蛊”兴起
从食材到“生命体”的奇幻蜕变
“面蛊”,这一名词听起来既神秘又充满科技感,实则是一种基于酵母发酵原理的简单生物过程。爱好者只需将适量的面粉与水混合,加入活性干酵母,静置一段时间,面团内部会因酵母的活动产生丰富的气泡,形成独特的纹理和形态。这一过程被赋予“养育”的意义,使得面团从一种简单的食材,摇身一变成为具有“生命感”的“宠物”。
爱好者会为“面蛊”取名、记录其生长,甚至为“发酵失败液化”的“面蛊”写下悼念文字,赋予其拟人化的生命意义。杭州一新手妈妈表示,她通过用“面蛊”制作面包的过程,不仅获得了烘焙的乐趣,更感受到“一种可控的生命力陪伴”。

抖音用户“小马的包子铺(早餐培训)”发布的“面蛊”视频(截图)。
与传统宠物不同,“面蛊”的生命周期短暂且可循环——从发酵到烘焙成食物,再到重新制作,这种“有限陪伴”满足了爱好者在快节奏生活中对低负担情感投射的需求。部分资深爱好者甚至通过持续“喂养”酵母菌,将“面蛊”保存数年之久,使其成为跨越时间的“生物艺术品”。
“面蛊”的兴起,迅速在网络上引发热议。年轻人作为网络文化的主力军,纷纷尝试制作并分享自己的“面蛊”作品。在社交媒体平台,“#面蛊#”“#生物艺术品#”等相关话题的讨论热度持续攀升,大量精美的“面蛊”照片和视频被上传、分享,进一步推动了这一现象的普及。
静态异宠
年轻人的情感寄托与创意展现
事实上,“面蛊”并非孤例。记者在网上搜索发现,近年来类似“面蛊”这样的新潮异宠逐渐盛行,养石头、养纸盒、养牙膏、养“芒狗”、养黏菌……“万物皆可宠”的年轻人正以创意打破传统养宠边界,给一个个看似无生命的物品赋予独特的情感价值和陪伴意义。
抖音用户“曳尾菌”发布的“斗菌”视频(截图)。
以养“芒狗”为例,养“狗”人将吃剩的芒果核清洗、风干后,用牙刷梳理出纤维状的“毛发”,再以丙烯颜料绘制五官,甚至喷洒香水增加“宠物感”,最终将普通果核“改造”成毛茸茸的“芒狗”。社交平台上,还有不少网友晒出自己的宠物黏菌,这些奇特的小生物不但形态各异、色彩斑斓,而且每一只都有其独特的个性和行为,吸引了大量关注。
国外,日本年轻人流行饲养苔藓微景观,通过每日喷水养护获得“微型自然”的治愈感;北欧则有“水晶花园”热潮,将矿物结晶视为“地质宠物”。
专家提醒
不可沉迷其中而忽略责任
年轻人爱上“面蛊”、石头、“芒狗”等静态异宠,对此,国家二级心理咨询师、广西妇联婚姻家庭纠纷调解专家库专家刘晓颖认为,这实际上反映了年轻人的一种情感陪伴需要。
刘晓颖表示,与饲养传统猫、狗、鱼等宠物相比,养静态异宠操作更简单。在繁忙的工作之余,通过养这些省心的静态异宠来获得成就感,进而得到心灵的寄托和放松,是年轻人的解压方式之一。这样的行为,与中国古代文人墨客寄情各种石头,通过藏石、赏石来寄托情感、陶冶情操、愉悦身心,进而得到精神升华有异曲同工之妙。
“一定要注意,养静态异宠不可沉迷其中。”刘晓颖认为,作为一名社会人应意识到自己的责任,要储备好知识、技能,以获得更加自主独立的人生,同时为社会的进步和发展出一份力,并担当起应有的责任。
南宁市融媒体中心 记者 何璨汐
来源: 南宁晚报